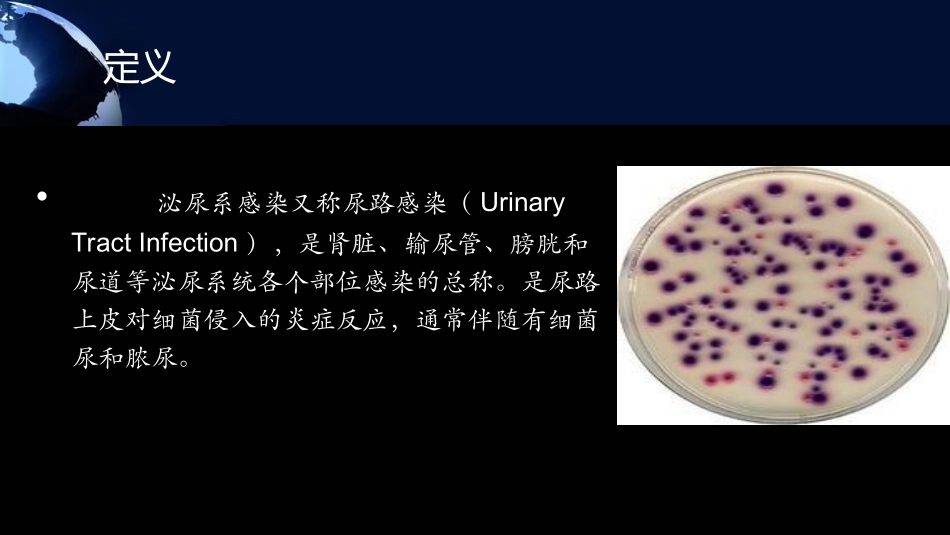
单纯性尿路感染_第3页

单纯性尿路感染六安市中医院泌尿外科六安市中医院泌尿外科汪勇副主任医师汪勇副主任医师泌尿系统基本概念•泌尿系统:男女共有•包括上尿路、下尿路•上尿路:肾、输尿管•下尿路:膀胱、尿道
上、下尿路的分界点:膀胱输尿管开口定义•泌尿系感染又称尿路感染(UrinaryTractInfection),是肾脏、输尿管、膀胱和尿道等泌尿系统各个部位感染的总称
是尿路上皮对细菌侵入的炎症反应,通常伴随有细菌尿和脓尿
尿路感染的分类•感染部位:--下尿路(尿道炎、膀胱炎)--上尿路(输尿管炎、肾盂肾炎、肾脓肿)•发作形式–初发或孤立发作–反复发作性感染:每年发作≥3次或每半年发作≥2次(不包括本次发作)•复发:病原菌同前,多发生于停药后2周之内•再感染:病原菌不同,多发生于停药后2周之外•病程:急性、慢性•基础疾患:单纯性、复杂性•无症状菌尿:患者无尿路感染症状,但中段尿培养连续两次(同一菌株),尿细菌数>105菌落形成单位(colony-formingunits,CFU)/ml
尿路感染的分类--按感染发生时的尿路状态分类•单纯性尿路感染(单纯下尿路感染和单纯上尿路感染)•复杂性尿路感染(包括导管相关的感染等)复杂性尿路感染(包括男性尿路感染)•尿脓毒血症•单纯性尿路感染是指发生于泌尿系统的解剖结构功能正常而又无糖尿病或免疫功能低下等合并症患者的尿路感染,短期抗菌药物治疗即可治愈,通常不会对肾脏功能造成影响
流行病学•尿路感染是仅次于呼吸道及消化道的感染性疾病
•全球每年1
5亿人罹患尿路感染,所消耗的医疗费用约为60亿美元
•美国每年超过700万人就诊(多为膀胱炎),超过100万人住院(多为肾盂肾炎)•尿路感染致休克而死亡者在所有因感染致死者中居第3位
•我国尿路感染约占院内感染的20
•尿路感染占社区感染的第2位,女性发病率远高于男性
•在女性,年龄每增加10岁发病率便增